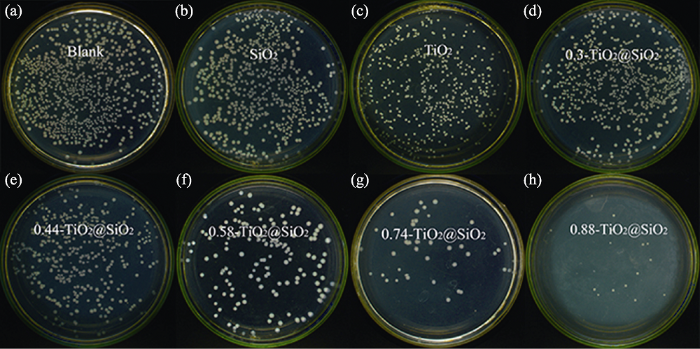

众所周知, TiO2因其绿色环保、无二次污染、性质稳定、制备简单和价格低廉等优异性能而成为较有前途的一种光催化抗菌剂[3]。通常, 锐钛矿相的TiO2具有最活跃的光催化结构[4]。但TiO2在应用方面仍存在很多不足, 例如纳米TiO2粒子易于团聚[5]、较小的表面区域、光生电子-空穴对的重组、吸附性能差等[6], 这些缺陷通常会降低光催化活性和抗菌效果。为了弥补这些缺陷, 获得高活性的TiO2光催化抗菌剂, 科研人员主要利用了负载技术[7,8], 引入另一种金属/非金属氧化物如SiO2、ZrO2、WO3和Fe2O3[9,10]对其进行改造, 并在其表面沉积贵金属[11](如: Ag、Pt、Au)以提高量子效率; 而SiO2是一种具有多孔结构的非晶态材料[12], 凭借其物化性质稳定、热稳定性高、比表面积大等特性而成为一种性能优异的载体[13]。
本研究以微米级介孔SiO2为载体, 制备了TiO2/SiO2复合材料, 以解决TiO2粉体团聚和回收再利用的难题, 同时利用SiO2具有的较大比表面积和吸附能力, 使得有机污染物和细菌能够有效地吸附到材料表面并与之发生作用, 提高光催化反应速率和抗菌效率, 并深入探讨复合材料在抗菌方面的机理问题。
1 实验方法
1.1 样品制备
按体积比1 : 1.5的比例将预热至90 ℃的水玻璃(工业)和碳酸氢钠溶液放入反应器中, 在温度90 ℃、转速300~500 r/min条件下进行反应, 反应后获得溶胶体系; 再次量取适量体积的水玻璃和碳酸氢钠溶液并预热至90 ℃, 然后降低反应器转速, 将预热好的水玻璃溶液和碳酸氢钠溶液依次加入反应器中, 充分反应20 min后获得凝胶体系, 用酸调节pH至6, 继续反应1 h, 反应停止后用去离子水抽滤洗涤3次, 最后置于100~120 ℃下干燥1~3 h, 即得二氧化硅粉体, 研磨后装袋备用。
称取制备的二氧化硅粉体与一定量无水乙醇相混合, 超声分散10 min, 使粉体均匀分散在乙醇溶剂中得到悬浮液A; 将装有悬浮液A的三口烧瓶置于恒温加热磁力搅拌器中, 设置温度为60 ℃, 磁力搅拌转速为600 r/min; 分别量取一定量的钛酸丁酯、4.3 mL异丙醇溶液依次加入三口烧瓶中得到混合液B, 搅拌2 min后, 滴加去离子水, 控制滴速为2.5 mL/min。之后, 用0.5 mol/L的硝酸调节pH至2左右, 继续搅拌反应5 h, 反应结束后趁热抽滤, 用乙醇洗涤2~3次, 置于100~120 ℃下干燥, 再经350 ℃高温煅烧2 h后得到TiO2@SiO2复合光催化抗菌材料。
改变钛酸丁酯的加入量, 分别制得复合物中钛与硅理论摩尔比为0.3、0.44、0.58、0.74、0.88的TiO2/SiO2复合光催化抗菌材料, 并标记为样品1至5。
本研究对照样为纯TiO2, 其制备同样采用水解法, 取一定量的钛酸丁酯与异丙醇混合, 加入去离子水反应5 h, 控制反应体系的pH至2左右, 反应结束后再经350 ℃高温煅烧2 h得到纯TiO2粉体材料。
1.2 物性表征
采用荷兰帕纳科X/pert-3型X射线衍射仪(XRD)对制备的样品进行晶型物相分析, 工作条件为Cu靶Kα射线(λ=0.154056 nm), 管电压40 kV, 管电流40 mA, 扫描范围2θ=10°~80°; 采用美国麦奇克Micratrac s3500型激光粒度仪及日本日立SU8020型高分辨场发射扫描电子显微镜(SEM)分析材料的微观形貌和尺寸, 并利用扫面电镜配套的能谱仪(EDS)对材料表面元素构成进行分析; 采用JW-BK22型比表面积及孔径测定仪(BET)测定材料对N2吸附-脱附等温线, 分析SiO2材料在负载前后的比表面积和孔径变化情况; 采用美国赛默飞公司ESCALAB 250Xi型X射线光电子能谱仪(XPS)测定了颗粒表面的元素组成和化学状态; 采用德国布鲁克公司的Tensor-Ⅱ型傅立叶变换红外光谱仪(FT-IR)作红外光谱扫描, 以表征材料的结构及基团变化情况, 测试波长范围为400~4000 cm-1, 扫描次数为16次; 采用FL-4600型荧光分光光度计测定活性氧含量。
1.3 光催化性能检测
采用UVA紫外光下降解甲基橙溶液来考查复合材料的光催化活性, 采用光化学反应器(CEL-LAM), 室温下以500 W高压汞灯作为紫外光光源。具体检测过程如下: 0.1 g样品分散于100 mL甲基橙溶液(20 mg/L)中, 并超声分散10 min, 超声完毕后在暗环境中静置30 min, 以达到固-液吸附平衡, 暗处理结束后, 取甲基橙原液, 测其最大吸光度值A0, 并记录最大吸光度值所对应的波长λ。接着进行紫外照射, 光源垂直照射在反应液面, 固定光源与溶液的垂直距离为20 cm, 磁力搅拌下反应 3 h, 每隔15 min取样, 离心后, 采用紫外分光光度计检测上清液在最大波长λ处的吸光度值, 记为At, 按照下列公式计算甲基橙溶液降解率η(式(1)):
式中: η为降解率, At为t时刻样品甲基橙溶液吸光度, A0为暗处理后初始甲基橙溶液吸光度。
1.4 抗菌检测
实验采用涂布平板法对制备的复合材料进行抗菌试验, 菌种选用BL21型大肠杆菌。抗菌实验过程如下: 首先配置LB琼脂培养基(胰蛋白胨5 g、酵母粉2.5 g、氯化钠5 g、蒸馏水500 mL, 琼脂7.5 g), 倒板备用; 再配置LB液体培养基(胰蛋白胨5 g、酵母粉2.5 g、氯化钠5 g、蒸馏水500 mL), 将大肠杆菌接种至液体培养基中, 培养至对数生长期, 接着将培养好的大肠杆菌菌液用缓冲液稀释至CFU为5×106 mL-1备用。称量0.1 g制备的样品置于已灭菌的试管中, 并用10 mL蒸馏水进行稀释, 移取100 µL稀释后的菌液至试管中摇匀, 放置在摇床上震荡30 min, 同时分别用UVA紫外光和可见光光照; 震荡完毕后, 用移液器移取100 μL菌液到固体培养基上, 均匀涂板, 置于37 ℃的恒温培养箱培养18~24 h; 采用抑菌圈测量及菌落计数仪(Czone 5F)进行活菌菌落计数, 与空白实验对比计算出抗菌率。
1.5 活性氧(ROS)检测
利用荧光探针DCFH-DA进行活性氧(ROS)检测, DCFH-DA本身不具有荧光性, 可自由穿过细胞膜, 进入细胞后, 被细胞内的酯酶水解成DCFH, 而DCFH不会透过细胞膜, 因此被聚集在细胞内。复合材料在一定条件下产生的ROS会穿透细胞壁和细胞膜进入体内, 将无荧光的DCFH氧化成具有荧光性的DCF, 即二氯荧光素[17,18]。且荧光强度与ROS的水平成正比, 因此通过荧光分光光度计进行荧光强度检测, 即可判断由复合材料产生并进入菌体内的ROS水平。具体检测过程如下: 移取培养好的大肠杆菌菌液至试管中, 向试管中加入DCFH-DA之后将试管放置摇床上震荡10 min, 加入一定量的TiO2@SiO2粉体处理细菌, 20 min后离心收集沉淀物, 并用磷酸缓冲液洗涤2次, 离心后收集到的沉淀物再次用磷酸缓冲液制成细菌悬液, 在固定激发波长492 nm下进行荧光强度检测。
2 结果与讨论
2.1 形貌表征
图1
图1
纯载体材料和复合材料的SEM照片
Fig. 1
SEM images of support and composites
(a) SiO2; (b) TiO2-doped SiO2
图2
表1 TiO2@SiO2复合材料元素含量分析结果
Table 1
| Element | wt % | at % |
|---|---|---|
| Ti | 28.40 | 13.57 |
| Si | 25.90 | 21.10 |
| O | 45.70 | 65.33 |
2.2 结构分析
图3是纯SiO2、纯TiO2和复合材料样品3的XRD图谱。如3(a)图谱所示, 纯SiO2仅在2θ=20°~30°处有一宽缓的衍射带, 且在其它角度下并没有出现明显的衍射峰, 表明SiO2为无定形态, 属于典型的非晶质。从纯TiO2图谱(b)可见, 在2θ角为25.44°、38.17°、48.13°、55.12°、63.17°、70.02°处出现明显的特征峰, 且所有衍射峰所在2θ角与锐钛矿型TiO2标准卡片(21-1272)的(101)、(112)、(200)、(211)、(204)和(220)晶面一一对应。从图谱(c)中可以清楚地观察到样品3特征峰对应的2θ角与纯TiO2特征峰对应的2θ角一致, 衍射峰较为尖锐, 且未发现其他晶型的衍射峰, 表明负载在SiO2表面的TiO2呈锐钛矿型, 且结晶度良好, 这与SEM分析结果相印证。
图3
图3
SiO2、TiO2和TiO2@SiO2的XRD图谱
Fig. 3
XRD patterns of SiO2, TiO2 and TiO2-doped SiO2
SiO2、TiO2和复合材料样品3的红外光谱图如图4所示。在3400 cm-1处的宽带对应于表面吸附的水和羟基, 1630 cm-1处出现的吸收峰是O-H键的弯曲振动[19]。1110 cm-1处的吸收峰是由SiO2中Si-O-Si键的不对称振动引起, 800 cm-1处对应于内部SiO4反对称和对称的伸缩振动峰, 470 cm-1的吸收峰对应于Si-O键的弯曲振动。Ti-O-Ti键出现在400~600 cm-1范围内[20,21]。TiO2@SiO2图谱在 959 cm-1左右出现Ti-O-Si的不对称伸缩振动[22], 这是由于Ti原子与SiO4四面体结合所引起; 而在SiO2图谱上949 cm-1附近出现的吸收峰则是由Si-OH键引起[23]。
图4
图4
TiO2、SiO2和TiO2@SiO2的红外光谱图
Fig. 4
FT-IR transmission spectra of TiO2, SiO2 and TiO2- doped SiO2
为进一步阐明TiO2与SiO2之间的界面作用, 测量SiO2和复合材料样品3的XPS光谱作为表征 (图5)。在图5(a)中, 样品3(0.58-TiO2@SiO2)O1s轨道的XPS光谱通过分峰拟合为三个光谱分量, 分别归因于Ti-O-Ti (529.6 eV)、Ti-O-Si (531.6 eV)、Si-O-Si (532.8 eV)键[24,25]。另外, 对比图5(b) SiO2和图5(c)样品3(0.58-TiO2@SiO2)Si2p轨道的XPS光谱可以清楚地看到在结合能为103.2 eV对应Si-O-Si键[26], 而在0.8 eV发生额外的组分(峰Ⅱ)为所述的Ti-O-Si键。所有上述分析进一步证实在TiO2和SiO2之间形成了界面Ti-O-Si键。
图5
2.3 粒径分析与比表面积
图6为纯SiO2和复合材料样品3的粒径分布图,由图可知, SiO2颗粒分布均匀, 平均粒径为24.34 µm, 负载TiO2后材料的平均粒径增长至24.49 µm, 由此说明复合材料覆盖了一层TiO2, 平均粒径增加0.15 µm。
图6
图6
SiO2和TiO2@SiO2(b)的粒径分布图
Fig. 6
Particle size distributions of SiO2 (a) and TiO2-doped SiO2 (b)
图7为材料的N2等温吸附-脱附曲线, 样品3、SiO2和TiO2的等温线根据国际纯粹与应用化学联合会(IUPAC)分类属于Ⅳ型曲线, 且在低相对压力下是可逆的。三条曲线分别在相对压力(p/p0)为0.7、0.8、0.4左右处出现明显的H1型滞后环[27] , 这与介孔的存在密切相关[28,29] , 由此说明三种材料均为介孔结构, 其中, 样品3和SiO2为无序的介观结构。三种材料的孔径分布通过BJH模型计算得出, 孔径大小: SiO2 > TiO2@SiO2复合材料 > TiO2。表2列出了SiO2、TiO2和样品3的比表面积和BJH吸附平均孔径数据, 对比纯SiO2材料, 在负载TiO2后, 从SEM看到大量微小的TiO2晶粒覆盖在材料表面并填充了载体SiO2中较大的孔道, 但TiO2更微小的介孔结构使得复合材料的孔道结构变得更为复杂, 表面更加粗糙, 导致复合材料的平均孔径减小, 比表面积增大, 使得复合材料的吸附性能更好。较大的比表面积能够提供更多的吸附中心和光催化反应中心[30], 有利于光电转化过程, 促进更多活性氧的生成, 也有利于材料与污染物或细菌的吸附接触[31], 从而提高光催化性能和杀菌性能。
图7
图7
不同样品的吸附-脱附曲线
Fig. 7
N2 adsorption-desorption isotherms with inserts showing pore size distributions of different samples by applying the BJH model
表2 SiO2、TiO2和TiO2@SiO2的比表面积和BJH吸附平均孔径
Table 2
| Sample | BET/(m2·g-1) | BJH Pore size/nm |
|---|---|---|
| 0.58-TiO2@SiO2 | 177 | 12.4 |
| SiO2 | 83 | 20.6 |
| TiO2 | 115 | 4.4 |
2.4 光催化活性分析
图8是不同Ti掺杂量的TiO2@SiO2复合材料及空白对照样的光催化降解趋势图。由图可知, 未加入复合材料时, 甲基橙溶液在紫外光照射3 h后的自然降解率仅为15%, 表明甲基橙的自身降解不明显; 而对于TiO2@SiO2复合材料, 随着样品中Ti含量增多, 甲基橙的降解率呈上升趋势, 当n(TiO2) : n(SiO2)=0.58时, 复合材料对甲基橙的光催化效果最佳, 105 min后的降解率已达到95%, 远高于同一时刻下其他几组样品的光催化活性; 当继续提高复合材料中的钛含量时, 降解率出现下降趋势, 这与Wang等[32]的研究工作所得趋势一致。根据Mohapatra等[33]的研究结论, 在固定光照条件下, 溶液中TiO2的含量与催化活性是相关的。TiO2在光照条件下产生光生电子和空穴, 一部分光生电子可以移动到材料表面, 与溶液中的含氧物质发生作用而生成活性氧, 另一部分光生电子则与空穴迅速复合, 失去活性。随着TiO2含量的增加, 激发的光生电子增多使得催化活性增强, 当TiO2含量超过某一数值后, 电子与空穴复合速率反而加大, 因此降低了催化活性。
图8
图8
不同Ti掺杂量TiO2@SiO2样品的光催化降解曲线
Fig. 8
Photocatalytic degradation of methyl orange by using TiO2-doped SiO2 with different Ti contents
(1) 0.3-TiO2@SiO2; (2) 0.44-TiO2@SiO2; (3) 0.58-TiO2@SiO2; (4) 0.74-TiO2@SiO2; (5) 0.88-TiO2@SiO2
2.5 抗菌检测分析
2.5.1 抗菌检测结果
在进行抗菌检测过程中, 首先验证UVA紫外光是否对细菌有杀灭作用。为避免大功率的紫外灯对活体细菌造成过大伤害, 本实验采用小功率(100 W)紫外灯进行照射。对空白菌液进行UVA紫外照射20~40 min, 照射完毕后涂板培养24 h, 实验结果证明UVA紫外光照对大肠杆菌没有杀菌作用, 因此抗菌实验方案可行。
图9
图9
UVA条件下SiO2、TiO2和不同钛掺杂量的TiO2@SiO2复合材料抗菌效果照片
Fig. 9
Antimicrobial effect of SiO2, TiO2 and TiO2-doped SiO2 composites with different Ti contents on E.coli under UVA irradiation
图10
图10
UVA条件下不同钛掺杂量对TiO2@SiO2材料抗菌性能的影响
Fig. 10
Effect of the antimicrobial property using TiO2-doped SiO2 composites with different Ti contents under UVA irradiation
表3 不同光照条件下的抗菌性能结果
Table 3
| Lamp-house | Material | E.coli-BL21 | |
|---|---|---|---|
| Number (after 24 h) | Reduction of bacteria/% | ||
| UVA | Blank | 833 | - |
| SiO2 | 788 | 5.4 | |
| 0.58-TiO2@SiO2 | 163 | 80.5 | |
| TiO2 | 586 | 29.6 | |
| Visible light | Blank | 808 | - |
| 0.58-TiO2@SiO2 | 198 | 65.5 | |
2.5.2 抗菌机理分析
本研究采用较弱的光照条件进行抗菌实验, 抗菌材料产生光生电子和空穴的速率较为缓慢, 所以体系中的活性氧一直处于较低的平衡状态, 随着TiO2含量的增加, 激发的光生电子增多使得催化氧化活性增强, 并逐渐趋于饱和平衡, 但复合速率尚未超过激发速率, 所以抗菌率呈现上升并趋于平缓的趋势。
抗菌机制过程如图11所示。
图11
图11
TiO2@SiO2复合材料的抗菌机制
Fig. 11
Probable antimicrobial mechanism of TiO2-doped SiO2 composites
2.6 ROS检测
ROS的存在使细菌细胞稳态破坏, 造成细菌细胞氧化损伤[37], 从而导致细菌的死亡。利用荧光探针DCFH-DA进行ROS检测的结果如图12所示, 未经染色的菌液本身是不具有荧光性的, 随着SiO2、TiO2、TiO2@SiO2复合材料的加入, 荧光强度显著增强; 并通过图12可看出, 染色的菌液在加入SiO2后, 荧光强度增加不多, 说明光催化活性不明显, 在加入TiO2或TiO2@SiO2复合材料后的荧光强度达到168.4和406.9, 远高于空白试验的荧光强度。该结果显示TiO2@SiO2复合材料具有明显高于纯TiO2的催化氧化活性, 在光照条件下可产生大量的ROS并有效扩散到细胞体内, 由此推断ROS的产生是TiO2@SiO2复合材料具有抗菌性能的主要原因之一。据文献报道, Ti-O-Si键的存在可有效抑制锐钛矿-金红石的相变, 而锐钛矿相更有利于光催化反应; 其次, TiO2@SiO2复合材料具有更大的比表面积, 可以提供更多的吸附位点和光催化反应中心。同时, Ti-O-Si键的存在说明复合材料存在TiO2/SiO2半导体异质结构[38], 可以有效地促进光生电子传递分离, 抑制电子和空穴的复合, 对增加ROS含量具有重要作用, 从而明显提高抗菌能力。
图12
图12
TiO2、SiO2和0.58-TiO2@SiO2材料的荧光图谱
Fig. 12
Fluorescence spectra of TiO2, SiO2 and 0.58- TiO2@SiO2 Right diagram shows the values of fluorescence with an excitation wavelength of 492 nm and an emission wavelength of 504 nm
3 结论
1) 采用溶胶-凝胶法和水解法制备TiO2@SiO2复合光催化抗菌材料是可行的。通过XRD、SEM、EDS、粒径和BET检测可以充分证明该复合材料是以SiO2为载体, 其表面成功地负载了锐钛矿型TiO2颗粒, 表面TiO2的结晶度良好。通过此方法增强了TiO2颗粒的分散性和晶型稳定性, 有效地解决了TiO2颗粒小、易团聚、难回收再利用等难题, 为复合材料的实际应用提供了方法。
2) TiO2@SiO2复合材料在甲基橙降解实验中表现出良好的光催化性能, 随着钛掺杂量的增加, 甲基橙脱色率呈先增大后减小的趋势, 钛掺杂量为0.58(摩尔比)时, 甲基橙在紫外光照105 min后的降解率为95%。良好的表面结晶度和较大的比表面积, 以及界面上Ti-O-Si键的存在都促进了光生电子的产生和分离, 提升了光催化效果。
3) TiO2@SiO2复合材料也表现出了优异的抗菌能力。该复合材料在UVA紫外光下对大肠杆菌的杀菌率达到92.7%, 在可见光下杀菌率达到65.5%, 对光源的适应性较广。根据FT-IR和XPS检测证明了Ti-O-Si键的存在, 并推测其更有利于羟基自由基等活性氧的产生, 同时荧光检测证明了复合材料所产生的活性氧大量迁移到了细菌体内, 并对细胞体产生了氧化损伤, 为进一步探索抗菌机理打下了坚实的基础。
参考文献
Heterogeneous photocatalytic degradation of organic contaminants over titanium dioxide: a review of fundamentals, progress and problems
Low Ag-doped titanium dioxide nanosheet films with outstanding antimicrobial property
Heterogeneous catalysis of alkene epoxidation
Physics and chemistry of photocatalytic titanium dioxide: visualization of bactericidal activity using atomic force microscopy
Preparation of TiO2 nanometer powders
Breakage of TiO2 agglomerates in electrostatically stabilized aqueous dispersions
Preparation, characterization and photocatalytic activity of manganese doped TiO2 immobilized on silica gel
Structure and photocatalytic performance of surface bond-conjugated TiO2/SiO2 Catalyst
Designed synthesis of SiO2/TiO2 core/shell structure as light scattering material for highly efficient dye-sensitized solar cells
Dopants for synthesis of stable bimodally porous titania
Sulfonated graphene oxide-ZnO-Ag photocatalyst for fast photodegradation and disinfection under visible light
Preparation and photocatalytic performance of silver modified white carbon black doped TiO2
Hydrothermal synthesis, characterization, and photocatalytic performance of silica-modified titanium dioxide nanoparticles
Synthesis of titania-silica mixed oxide mesoporous materials, characterization and photocatalytic properties
Titania versus zinc oxide nanoparticles on mesoporous silica supports as photocatalysts for removal of dyes from wastewater at neutral pH
Preparation, photocatalytic property and antibacterial property of Ag@TiO2@SiO2 composite nanomaterials
Recent advances in fluorescent probes for the detection of reactive oxygen species
Titanium dioxide nanoparticles induce bacterial membrane rupture by reactive oxygen species generation
Characterization and sintering behaviour of submicrometre titanium dioxide spherical particles obtained by gas-phase hydrolysis of titanium tetrabutoxide
Titania-silica mixed oxides: I. Influence of Sol-Gel and drying conditions on structural properties
Titania-silica as catalysts: molecular structural characteristics and physico-chemical properties
Titania-silica: a model binary oxide catalyst system
Infrared absorption spectra and structure of TiO2-SiO2 composites
Preparation of novel Cu/TiO2 mischcrystal composites and antibacterial activities for Escherichia coli under visible light
Thermally stable SiO2-doped mesoporous anatase TiO2 with large surface area and excellent photocatalytic activity
Enhanced photocatalytic properties of core@shell SiO2@TiO2 nanoparticles
Reporting physisorption data for gas/solid systems with special reference to the determination of surface area and porosity
Fabrication of microporous and mesoporous carbon spheres for high-performance supercapacitor electrode materials
G5-94 standard reference test method for making potentiostatic and potentiodynamic anodic polarization measurements
Enhanced photocatalytic performance of titania-based binary metal oxides: TiO2/SiO2 and TiO2/ZrO2
Synthesis and photocatalytic properties of highly stable and neutral TiO2/SiO2 hydrosol
Photocatalytic degradation of methylene blue and inactivation of gram-negative bacteria by TiO2 nanoparticles in aqueous suspension
Photocatalytic activity of sulfate modified titania 3: decolorization of methylene blue in aqueous solution
Progress of study on the anti-bacterial materials of Ag-embedding titanium oxide
Synthesis, characterization and antibacterial properties of core-shell structure Ag+-loaded nano-titania doped with rare earth ion antibacterial agent
Nanometer TiO2/SiO2 composite antibacterial materials for foodstuffs
Zinc oxide nanoparticles dispersed in ionic liquids show high antimicrobial efficacy to skin-specific bacteria
Recent progress on nano- heterostructure photocatalysts for solar fuels generation